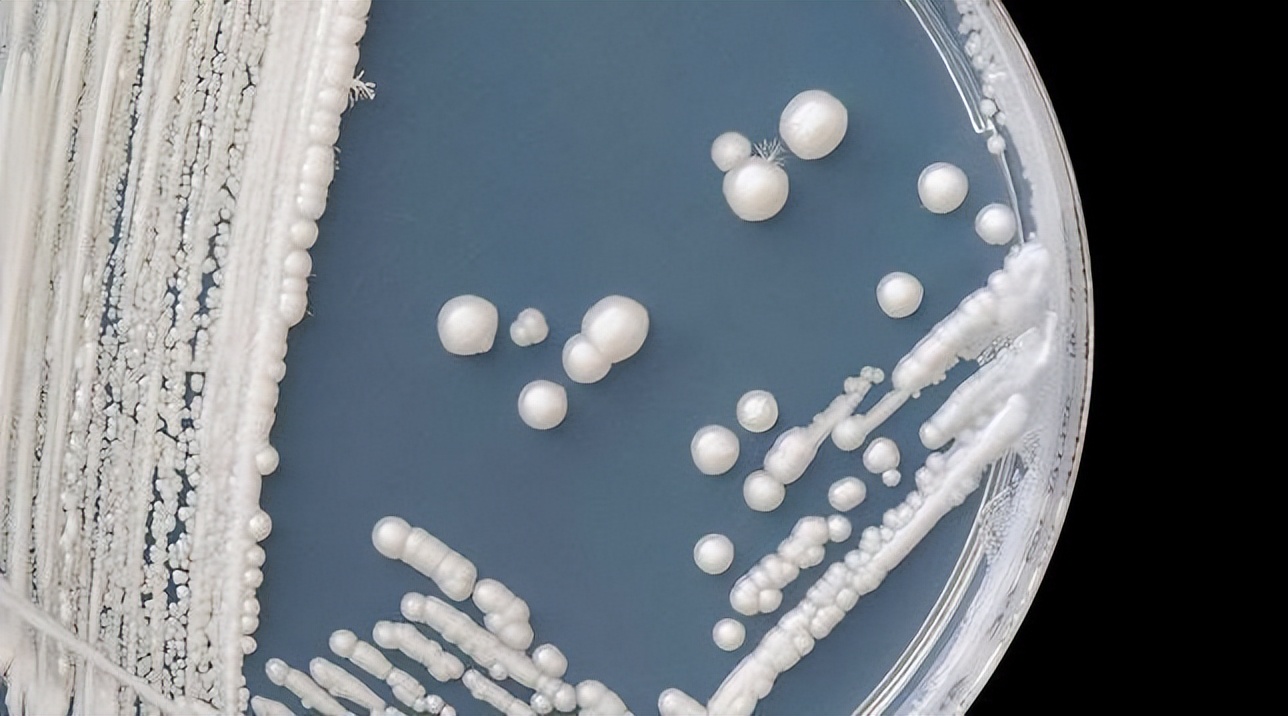
金黄色葡萄球菌的微生物特性,金黄色葡萄球菌的培养特性

引言
在生物膜相关感染的情况下,白色念珠菌和金黄色葡萄球菌通常被共同分离,白化病菌(C. albicans)可通过从圆形酵母形态转变为侵入性菌丝形式而引起全身性疾病。
笔者在本文中描述了一种新的策略,通过该策略金黄色葡萄球菌能够侵入宿主(主要为鼠类)组织并通过粘附白色念珠菌的侵入性菌丝元素进行传播 ,探讨葡萄球菌与念珠菌菌丝成分在体外和离体中是否具有特异性结合。

一、葡萄球菌突变体结合白色念珠菌的能力
鉴于C. albicans通过其侵入性菌丝粘附和穿透组织的倾向,结合S. aureus对菌丝的高体外亲和力,推测与C. albicans 的共定植可能提供S. aureus是可行的。
金黄色葡萄球菌能够进入血管系统由于最近在口腔中发现了金黄色葡萄球菌以及和白色念珠菌, 我们试图使用标准的念珠菌病小鼠模型来测试它们在口腔*共中**同定植的影响。
进行了舌头组织病理学分析,并显示了侵入性白色念珠菌菌丝与粘附的金黄色葡萄球菌对组织的上皮下共渗透,这种相互作用在白色念珠菌Als3p 菌丝蛋白的突变体中不存在,但在通过互补恢复 Als3p 时得到恢复。
研究开发了一种新型的口腔共定植小鼠模型,以监测免疫功能低下的宿主中粘膜共定植到全身性疾病的发展和潜在进展,在此模型中小鼠仅在被金黄色葡萄球菌共同定植时才会患上具有高发病率和死亡率的播散性葡萄球菌病和白色念珠菌。

虽然这种“微生物搭便车”现象已在其他体外系统中发现,特别是如果这种微生物感染协同作用发生在其他通常会发生共同定植的区域,例如肠道、生殖道、感染和失活的皮肤或皮肤的腋窝或腹股沟区域。


由于定植和生物膜形成是致病过程发展的先决条件,因此进行了体外研究以可视化金黄色葡萄球菌和白色念珠菌菌株在多微生物生物膜*共中**存时的相互作用。
金黄色葡萄球菌和白色念珠菌突变体和互补菌株的混合物种生物膜在体外生长,并通过 PNA-FISH 染色显示,其中金黄色葡萄球菌显著减少与表达受体的菌株相比,观察到缺乏 Als3p ( als3 Δ/Δ) 的白色念珠菌菌株对菌丝的粘附。

重要的是在生物膜流动系统中通过荧光显微镜实时监测和捕获金黄色葡萄球菌最初粘附在导致成熟生物膜发展的菌丝上, 可以看出金黄色葡萄球菌GFP在进入流动池后立即迅速且特异性地粘附到附着在流动池表面的菌丝上。
当更高细胞密度的金黄色葡萄球菌流过系统时,会看到更快速和显著的粘附,导致在粘附过程开始后 5 分钟内形成成熟的混合物种生物膜。

二、C. albicans相互作用
为了确定负责菌丝结合的特定葡萄球菌因子,WT金黄色葡萄球菌菌株 JE2 和 25 种不同的金黄色葡萄球菌菌株在先前描述的粘附素中发生突变,分别添加到 SC5314白色念珠菌生物膜中。
确定每个突变体附着在 SC5314 菌丝上的细胞百分比,并与 WT金黄色葡萄球菌与 SC5314 或 SC5314 als3 Δ/Δ共培养的菌丝附着百分比进行比较。

发现 WT JE2 细胞与菌丝结合的百分比与葡萄球菌菌株 M2 的百分比相同,JE2 的使用一种在系统发育上与 M2 菌株不同的金黄色葡萄球菌菌株,为这种金黄色葡萄球菌–C. albicans相互作用是特定于物种的,而不仅仅是特定于菌株的。

测试的几种葡萄球菌突变体结合白色念珠菌的能力在统计学上显着降低,包括 NE728(纤连蛋白结合蛋白 B 中的Δ)附着率为 62%,NE800(sasF中的Δ,一种假定的表面锚定蛋白)附着率为 61%附件和 NE1190(Atl 中的Δ,一种推定的N-乙酰胞壁酰-l-丙氨酸酰胺酶)具有 52% 的附件。

其他五个粘附素突变体表现出类似的结合能力降低(52-65% 附着)白色念珠菌,尽管由于较大的sd ,这些差异在统计学上并不显著。
粘附素中创建单突变体、双突变体、三突变体或八突变体已被证明可以消除金黄色葡萄球菌在体内形成生物膜和存活的能力。
此类金黄色葡萄球菌突变体在与白色念珠菌共同感染的情况下不再能够系统性传播无论深层组织输送的机制如何。

由于无法断定缺乏金黄色葡萄球菌引起的全身性疾病是否是白色念珠菌菌丝结合减少或无法在宿主内存活的产物,随后的研究确定了体内菌丝相互作用所需的葡萄球菌粘附素的组合。
为了研究 Als3p 在共定殖的侵入机制中的作用进行了实验,其中允许两种微生物在离体感染的切除舌头上相互作用,与非生物表面的图像类似,金黄色葡萄球菌与Als3p 受体,但对缺乏受体als3 Δ/Δ。

所有三种白色念珠菌菌株中,可以看到金黄色葡萄球菌和白色念珠菌在舌头表面形成多微生物生物膜,重要的是除了单纯的共定植外,该模型还证明了金黄色葡萄球菌的组织与白色念珠菌的侵入性菌丝共同渗透到上皮下。
一个依赖于 Als3p 的过程,因为金黄色葡萄球菌没有与als3 Δ/Δ共同渗透。我们确实注意到与使用共聚焦显微镜对多微生物生物膜发育的体外分析相比,这些研究中葡萄球菌菌丝结合显著减少。

这些差异可能是由于唾液成分和舌头环境的结构复杂性,以及舌头产生宿主防御因子。

三、小鼠口腔共定植体内模型
开发了微生物共定植的动物模型,以研究微生物相互作用对免疫功能低下宿主粘膜组织的致病影响,小鼠口腔单独或联合接种金黄色葡萄球菌和白色念珠菌,从安乐死的动物身上采集舌头和肾脏。
还单独或与金黄色葡萄球菌联合接种白色念珠菌 als3 Δ/Δ 突变体和als3 Δ/Δ ALS3互补菌株, 采集的舌头的临床表现与晚期念珠菌病一致,诊断由组织病理学证实。

单独被金黄色葡萄球菌定殖的动物都没有表现出明显的疾病或体重减轻症状,并且都存活到实验结束。单独感染白色念珠菌的小鼠表现出口腔念珠菌病的症状,并且由于体重显著下降,一半的小鼠需要早期安乐死。
这些小鼠都没有表现出全身感染的症状,这表明体重减轻完全是由于口腔念珠菌病,而不是由于侵入性感染,单独使用的所有三种白色念珠菌菌株的存活率没有显著差异。

与口服接种任一单一物种的动物相反,同时接种含有完整 Als3p(WT SC5314 或 SC5314 als3 Δ/Δ ALS3补充)的金黄色葡萄球菌和白色念珠菌的动物表现出全身感染的迹象,包括脱水和嗜睡。
根据马里兰大学机构动物护理和使用委员会的人道终点指南,该组中的小鼠体重明显下降,需要在接种后 6 天 (dpi) 进行早期安乐死和停止实验。
所有这些动物都在实验结束前死于感染,这由人道终点确定。 相比之下与缺乏 Als3p 的金黄色葡萄球菌和白色念珠菌共定殖的组中没有一只动物表现出全身感染的证据,并且这些小鼠中的大多数 (83%) 存活到实验结束。

为了诊断患病动物的发病原因,采集舌头和肾脏并进行培养以鉴定微生物的存在,从舌头中回收的白色念珠菌的 cfu 没有明显差异,无论使用哪种白色念珠菌菌株以及单独接种还是与金黄色葡萄球菌共同接种。
白色念珠菌没有表现出任何缺陷在没有 Als3p 的情况下在舌头上定殖。另一方面,与单独接种金黄色葡萄球菌相比,金黄色葡萄球菌在与任何白色念珠菌菌株共同接种时表现出增强的舌头定植。


与als3 Δ/Δ相比,具有功能性 Als3p 蛋白的菌株从肾脏中回收金黄色葡萄球菌和白色念珠菌证实了表明全身性疾病的症状。 从与表达完整 Als3p(WTSC5314 或 SC5314 als3 Δ/Δ ALS3互补)的白色念珠菌共感染的小鼠中回收了大量金黄色葡萄球菌。
在未接种白色念珠菌或接种白色念珠菌的小鼠的肾脏中未发现金黄色葡萄球菌缺少 Als3p 的白色念珠菌。从共接种金黄色葡萄球菌和 WT白色念珠菌的小鼠肾脏中回收了显着的白色念珠菌cfu 。

这与单独接种白色念珠菌或与缺乏 Als3p 的金黄色葡萄球菌和白色念珠菌共同接种的小鼠形成对比,其中大多数小鼠的肾脏中没有白色念珠菌。
aureus和C. albicans能够在有或没有 Als3p 表达的情况下在舌头的上皮表面形成致密的多微生物生物膜, 没有 Als3p 的情况下金黄色葡萄球菌无法进入血流并传播,表面上是由于缺乏与穿透性菌丝的结合。

白色念珠菌和金黄色葡萄球菌在免疫功能低下动物的口腔粘膜上的共同定植可能导致具有高发病率和死亡率的全身性金黄色葡萄球菌感染。
多种微生物侵袭代表由多种微生物物种的存在引起的表现, 这些微生物物种可能协同作用导致复杂的感染过程,尽管此类感染很严重, 但多种微生物侵袭的研究领域,尤其是那些涉及多种病原体(如真菌和细菌)的感染源仍处于起步阶段。

白色念珠菌和金黄色葡萄球菌是动物体粘膜表面的常见定植者,表现出很强的粘附宿主组织和产生耐药性的能力,以前没有进行过研究它们在共定植宿主粘膜组织时相互作用的影响。
其他五种葡萄球菌突变体也有类似的结合减少(尽管这些与 WT 菌株在统计学上没有显着差异),考虑到金黄色葡萄球菌中粘附素结合伙伴的冗余性,这并不奇怪。

与 Als3p 缺陷突变体结合的 JE2 WT 菌株和与WT白色念珠菌结合的任何金黄色葡萄球菌突变体均未显示结合减少至不到 50%,这可能是由于其他蛋白质在白色念珠菌菌丝上的表达可能在金黄色葡萄球菌中起次要作用坚持。
一种这样的蛋白质是 Als1,在早期的研究中显示它在体外结合金黄色葡萄球菌中发挥作用, 尽管与 Als3p 相比作用要小得多, C. albicans als3 Δ/Δ 突变体和 WT 菌株之间的明显差异,两者都在菌丝结合方面。

总结
笔者通过此文阐明了细菌病原体金黄色葡萄球菌和机会性真菌病原体白色念珠菌在多微生物生物膜生长过程中的协同相互作用,为此提出术语“微生物搭便车”。
这些不同且重要的共生体和机会性病原体之间的相互作用具有重要的意义,因此表征它们复杂的相互作用是了解它们在宿主*共中**存性质的重要一步。

尽管需要进行回顾性和前瞻性研究, 但我们的研究结果提倡对口腔念珠菌定植进行筛查,以此作为预防细菌侵袭感染的措施。
参考文献:
- 周文婷;李琛妍;黄凯黎;董蕙华;黄雯,《白色念珠菌菌丝形成与黏附侵袭致病的调控机制研究》
- 王东月; 李运清,《白色念珠菌菌丝的形成机制及防治》
- 刘贤;许珊;沈一鸣;亢胜男;刘景仑,《多肽bCAT联合卡泊芬净对白色念珠菌菌丝及成熟生物被膜的作用》